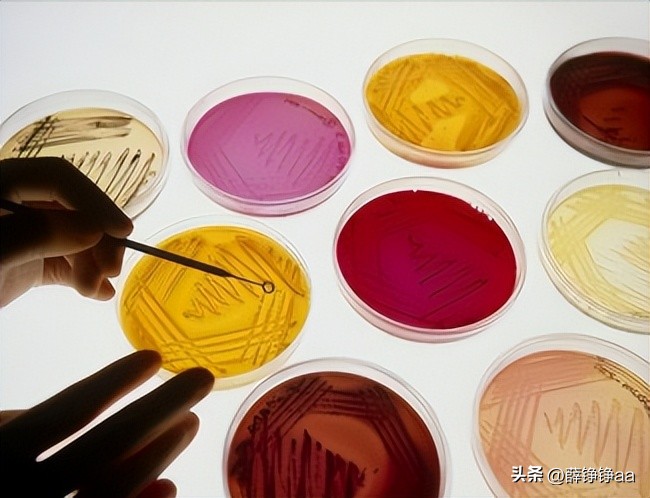
番茄青枯病害鉴别,分离番茄茎腐病真菌的方法
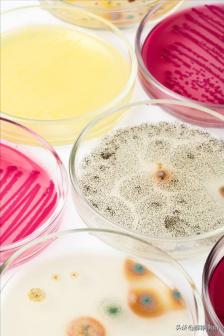
番茄青枯病害鉴别,分离番茄茎腐病真菌的方法
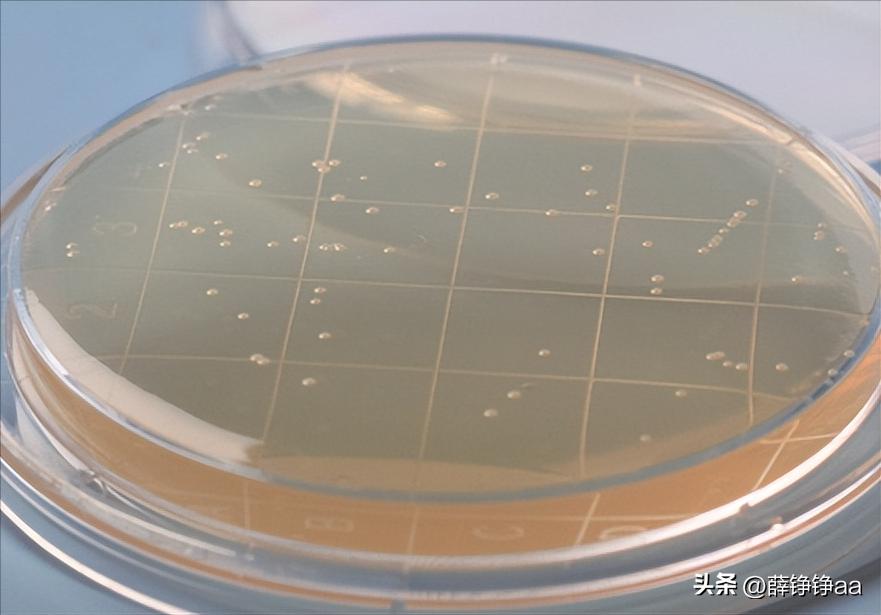
番茄青枯病害鉴别,分离番茄茎腐病真菌的方法

点击右上方关注,解锁每天好文章
文 | 薛铮铮aa
编辑 | 薛铮铮aa
前言
蔬菜是人类日常饮食中不可或缺的一部分,同时也面临着各种病害的威胁,其中最常见的问题之一就是 侵略性 较强的病原体。通过研究番茄以及其他蔬菜的分离物,可以更好地了解它们最具侵略性的特征。
为了分离引起蔬菜软腐病的病原体,实验室使用营养琼脂和富集培养基(以甜椒为宿主)技术对土豆、番茄、胡萝卜、辣椒和甜椒的患病样品进行了分析。

成功分离出的病原体通过亚培养纯化,生化测试鉴定出胡萝卜炭疽杆菌,并通过接种青番茄果实确认其致病性。对分离物进行侵染性测试,以找出在番茄上产生最严重软腐病,最具侵略性的物质。
采用四次重复的完全随机设计,并使用LSD(最小显著差异)检验分析数据。在评估五个分离物对番茄果实的侵略性时,发现辣椒分离物是最具侵略性的,其次是番茄和土豆分离物,分别产生了22.3毫米、7.9毫米和7.8毫米直径的软腐病病斑。

番茄和细菌性疾病之间的关系
番茄对健康平衡的饮食有益,且对心脏等器官有好处。且品种繁多,可以用做沙拉,也可以做酱料、汤和肉类或鱼类菜肴,还可以制成果汁和番茄酱。它们富含矿物质、维生素、必需氨基酸、糖和膳食纤维。

黄色番茄比红色番茄含有更多的维生素A,但红色番茄含有番茄红素,这是一种最强大的天然抗氧化剂,特别是在煮熟的番茄中,可以预防致癌物质,还可以改善有害紫外线对皮肤造成的损伤。
番茄受到很多种病原体的攻击,如真菌、线虫、细菌、病毒和类毒素。在细菌性疾病中, 软腐细菌 (Erwinia)是非常重要的,且有很多种。而Ecc 是一种革兰氏阴性细菌,可以独立生存,也可以成对和链状聚集。它不形成孢子,具有周纹鞭毛,是一种厌氧性兼性厌氧菌。

这其中,催化酶阴性和氧化酶阳性,会产生一系列外源性 植物细胞壁降解酶 ,如降解果胶的果胶酶、降解纤维素的纤维素酶、半纤维素酶、阿拉伯糖酶、青黛酮酸酶和蛋白酶。这些微生物不断侵袭土豆和其他蔬菜作物,使植物组织变软、多水分,最终变得黏滑和发臭。
就研究番茄和其他蔬菜软腐病等细菌性疾病而言,需要对疾病的不同方面进行详细研究,病原体特征研究就是其中重要的方面之一。对病原体进行特征研究有助于更好地理解它,进而帮助我们找到更好的抗病策略。

实验材料和方法
研究人员从市场上收集了 受感染 的土豆、胡萝卜、番茄和辣椒样品,经过清洁处理后,用0.5%次氯酸钠溶液进行表面消毒(几秒钟),用无菌蒸馏水冲洗,在无菌0.85%盐水溶液中使用无菌研钵在无菌条件下研磨,得到的细菌悬浮液静置几分钟。
然后将该悬浮液划线于含有营养琼脂(NA)的培养皿表面,并在30°C下孵育24小时。在NA上生长的单个菌落被挑选出来,再次划线于营养琼脂(NA)培养皿上,接着在30°C下孵育另外24小时,这个过程重复多次以获得纯培养物。
营养琼脂 是一种非选择性培养基,有时会出现与此培养基上无关的和腐生菌过度生长的问题。为了解决这个问题,有时会使用青椒作为软腐病菌的富集宿主,随后在营养琼脂上分离。
然后用无菌牙签刺入患病组织,接着刺入青椒中,把接种的青椒与湿润的组织放入塑料袋中,在30°C下孵育24小时,得到烂软的青椒用于之前描述的细菌分离方法。
研究人员使用特定的生物化学测试进行鉴定,包括KOH试验、过氧化氢酶试验、对5%氯化钠的耐受性、厌氧生长、粘液生长、在YDC上产生黄色色素、对红霉素的敏感性以及在37℃下的生长能力。

首先进行氢氧化钾(3%)测试,研究人员准备好新鲜的 3%氢氧化钾 (KOH)溶液,并将一滴该溶液放在常规显微镜玻片上。将24小时的细菌培养物放入这一滴溶液中,并搅拌10秒钟。
如果用牙签提起时,细菌悬浮液形成纤维状,那么说明是革兰氏阴性。而如果悬浮液呈现水样悬浮液(提起时没有黏性纤维),则说明为革兰氏阳性结果。接着对每个分离物都进行了氢氧化钾(3%)测试。

接着,研究人员进行了触酶试验,他们在显微镜玻片上放一滴 过氧化氢(H2O2) ,并将细菌细胞与这一滴过氧化氢混合。如果产生气泡,表示结果为阳性反应,如果没有气泡产生(对照组),则为阴性反应。
下面测试的是:5%氯化钠(NaCl)的耐受性,使用含有5%氯化钠(NaCl)的营养琼脂培养基,将细菌分离物接种到培养基上,然后将接种的培养皿在27℃下孵育24小时。
如果细菌在这个培养基上生长,就表示它们耐盐性较好。而对照组的培养皿上没有生长,就表明它们耐盐性较差。
依次是厌氧生长测试,研究人员首先制备了 营养琼脂培养基(NA) ,将其倒入试管中(每个试管5毫升),然后盖上并在121°C和15磅/平方英寸的压力下灭菌20分钟。
灭菌后,含有培养基的试管放在层流罩内静置冷却,并用细菌接种针在培养基上进行刺穿接种。每个分离物使用一个单独的试管,未接种的试管作为对照组。
试管内的培养基顶部覆盖有凡士林液体,以避免氧气条件,然后在27°C下孵育48小时。如果培养基上出现任何生长,则被视为厌氧生长的阳性结果。

接下来进行粘液生长实验,将含有LB培养基的琼脂平板上接种 细菌分离物 ,然后在27°C下孵育24-48小时。
如果在这个培养基上产生过多的粘液,称之为粘性菌落,当用牙签捞取菌落时,便可以明显观察到。
此测试是YDC上的黄色颜料,制备YDC(酵母葡萄糖碳酸钙)培养基,需酵母提取物10克,碳酸钙20.0克,葡萄糖20克,琼脂15克,蒸馏水1升。

然后将其放在121°C下灭菌15分钟,等培养皿固化时,研究人员会用24小时的培养物进行斑点接种。
接种的培养皿被标记、密封,并在27°C下孵育24小时。与对照组相比,在这个培养基上产生黄色菌落被视为阳性结果。
而测试红霉素的敏感性,则需制备改良的LB培养基(Bactotrypton 10.0克,Bacto酵母提取物5克,氯化钠10克,琼脂15克)一升;其中25毫升分装到5个小试管中(每个试管5毫升)。

剩下的培养基和试管都用 铝箔 覆盖,在121°C的高压灭菌器中灭菌20分钟。灭菌后,将培养基倒入培养皿中,等待固化。
这个培养基被称为基础层,小试管仍然留在高压灭菌器中以避免固化。在基础层固化后,液体培养基(稍微冷却但未固化)接种200微升的细菌悬浮液(108 cfu/ml)。
试管中接种的5毫升培养基倒在每个培养皿的基础层上,轻轻摊开并允许固化,这个顶层连同基础层被称为种子层。

商用抗生素纸片含有 红霉素 (15微克/纸片),无菌地放置在种子层的表面上,每个培养皿中间放置一片纸片。把培养皿放在27°C下孵育48小时,测量每个分离物周围的抑制区直径(以毫米为单位)。
为了确定分离物是Eca、Ecc还是Ech(Ecc和Ech可以在较高温度下生长,但Eca不能),研究人员会用营养琼脂培养基对细菌分离物进行划线接种。
这些培养皿连同对照一起在37°C下孵育24小时,细菌的生长结果表明是阳性。
至于分离物,研究人员会在番茄(Lycopersicum esculentum)上进行致病性测试,他们会使用纯净的菌落对青番茄果实进行 致病性测试 ,采用了CRD(完全随机设计),每组实验进行了四次复制。
用牙签接种了番茄果实,并将其放入塑料袋中,同时加入湿的纸巾。把袋子订好,在30°C下孵育24-48小时。
测量软腐病病斑的大小(以毫米为单位),给出阳性结果的菌落被保存在70%甘油溶液中(将0.5毫升细菌悬浮液加入0.5毫升无菌甘油溶液),并存储在-20°C或-80°C。培养物也被保存在0.85%无菌盐水溶液中,并存储在4°C。

根据病症、致病性、菌落形态和生化测试,我们对这些分离物进行了鉴定。在培养28小时后,营养琼脂上的菌落呈现透明、圆形、凸起、有光泽且呈奶白色的形态,培养温度为27℃。
所有五个分离物都能在厌氧条件下生长,对5%氯化钠(食盐)耐受,并在YDC培养基上产生黄色素,同时具有阳性催化酶反应、革兰阴性特性。
此外,这些分离物能够在37℃下生长,并且对红霉素不敏感。

最后两个测试(即在37℃下的生长和对红霉素的敏感性)是Ecc分离物的特异性,并将结果进行比较。通用生化测试的结果,如厌氧生长、YDC上的黄色素、盐耐受等,确认细菌分离物属于 厄尔温氏菌属 。
为了确定这些分离物是否为Ecc,并据此对其特性描述,进行了关键诊断测试。如,在37℃下的生长和对红霉素的敏感性。这些分离物能够在37℃下生长并且对红霉素不敏感,表明它们是Ecc而不是Eca或Ech。
Eca通常不能在37℃下生长,而Ech对红霉素敏感。其中土豆分离物对红霉素具有弱敏感性。这并不奇怪,因为同一物种的某些菌株的结果可能不同,发现他们的Eca和Ecc菌株对红霉素不敏感。

对此,所有的分离物都会在青番茄果实上进行侵染性测试。图表显示,在不同的分离物中,它们引起青番茄果实 软腐能力 存在显著(P≤0.05)差异。所有的分离物都具有致病性,并且引起不同程度的软腐。
其中辣椒分离物引发了最严重的腐烂,其次是番茄和土豆分离物。而在对健康寄主进行接种时,所有分离物都表现出致病性。

只是,当对番茄果实进行测试时,致病程度存在显著差异(P≤0.05)。预计番茄分离物会引起最严重的腐烂,但辣椒分离物表现出更强侵染能力。
结果表明,Ecc菌株没有特定宿主选择性,而是具有广泛的宿主范围。这些结果与文献一致,显示在结球茎上的侵染能力存在显著差异(P≤0.05),但一个宿主中的相对侵染力并不总是与其他宿主的侵染力或致病性相关联。

结论
通过生化测试,如厌氧生长、YDC上的黄色素和盐耐受性,确认细菌分离物属于厄尔温氏菌属(Erwinia spp.),而物种特异性测试则确认了分离物为Ecc。
软腐病的发展受到环境因素的影响,潮湿的环境和高温是软腐病菌繁殖和侵染的理想条件,它们能够迅速生长并引起病害的扩散。此外,缺乏适当的卫生管理和合理的农业措施也容易造成软腐病的流行。
通过分析番茄以及其他蔬菜的分离物,了解到软腐病最严重的特征包括:由一些细菌引起、产生果胶酶、纤维素酶等降解酶类物质、产生毒素干扰植物生理过程、受环境因素影响等。
深入研究这些特征可以帮助我们更好地防控软腐病,保障蔬菜生产的健康和稳定。
